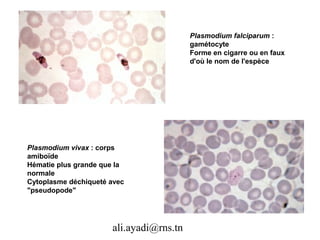
Plasmodium falciparum :
                                         gamétocyte
                                         Forme en cigarre ou en faux
                                         d'où le nom de l'espèce




Plasmodium vivax : corps
amiboïde
Hématie plus grande que la
normale
Cytoplasme déchiqueté avec
"pseudopode"




                      ali.ayadi@rns.tn

Le document présente des informations détaillées sur divers parasites, comprenant leurs morphologies, tailles et modes de transmission. Une attention particulière est accordée aux œufs et aux formes larvaires des parasites, ainsi qu'aux conséquences des infections parasitaires sur la santé humaine. De plus, des détails histologiques et des observations cliniques sont fournis pour différents types de parasites, tels que les helminthes et les protozoaires.